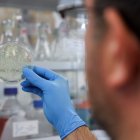
Investigadores descubren una posible nueva variante de la covid-19 en Bélgica.

La variante británica es más "transmisible" pero no aumenta gravedad de covid
Dos nuevos estudios no hallaron evidencias de que personas con esta variante experimentaran peores síntomas o mayor riesgo de desarrollar covid de larga duración frente a otros infectados con una cepa distinta

Sin embargo, la carga viral y el número "R" (reproductivo) fueron mayores en el caso de la citada variante, lo que refuerza la evidencia de que esta es más transmisible que la primera cepa detectada en Wughan.
La variante del coronavirus llamada B.1.1.7. (británica) es más "transmisible" pero no incrementa la gravedad de la enfermedad, según señalan los hallazgos de dos nuevos estudios difundidos este lunes en The Lancet.
Ambas investigaciones, publicadas respectivamente en las revistas The Lancet Infectious Diseases y The Lancet Public Health, no hallaron evidencias de que personas con la variante B.1.1.7. experimentaran peores síntomas o un mayor riesgo de desarrollar covid de larga duración frente a otros infectados con una cepa distinta del virus.
Sin embargo, la carga viral y el número "R" (reproductivo) fueron mayores en el caso de la citada variante, lo que refuerza la evidencia de que esta es más transmisible que la primera cepa detectada en Wughan (China) en diciembre de 2019.
En el artículo difundido en The Lancet Infectious Diseases participaron 19 pacientes ingresados en el hospital universitario University College London y el de North Middlesex University Hospital entre el 9 de noviembre y el 20 de diciembre de 2020, un momento crítico en el que la cepa original y la citada variante circulaba en Londres y el programa de vacunas apenas había empezado.
Los autores compararon la gravedad de la enfermedad en pacientes con y sin la B.1.1.7. y calcularon la carga viral pero no hallaron evidencias de asociaciones entre esa variante y un aumento en la gravedad de la enfermedad.
Entre 341 pacientes cuyos test de covid fueron secuenciados, los expertos identificaron, entre otros hallazgos, que el 58 % tenía la B.1.1.7. y un 42 % no. De aquellos que se infectaron con la B.1.1.7. el 36 % se puso gravemente enfermo o murió frente a un 38 % de los que se infectaron con una cepa diferente a la citada.

Ciencia y Tecnología
Coronavirus: Razones para no relajarse durante el proceso de vacunación
Gilson Pinargote
Eleni Nastouli, de la fundación hospitalaria University College London Hospitals NHS Foundation Trust y del UCL Great Ormond Street Institute of Child Health, destacó que "una de las verdaderas fortalezas del estudio es que se llevó a cabo al mismo tiempo en que la B.1.1.7. emergía y se propagaba por Londres y el sur de Inglaterra".
Los autores también admitieron limitaciones en su estudio, como que no tuvo en cuenta otros tratamientos recibidos por los pacientes o la posibilidad de que estos hubieran recibido asistencia respiratoria por motivos diferentes a la covid-19.
Por su parte, The Lancet Public Health difundió otro estudio que analizó datos de 36.920 usuarios británicos recabados por una aplicación de estudios de síntomas de covid-19, que dieron positivo entre el 28 de septiembre y el 27 de diciembre de 2020.
Los informes de resultados y síntomas se combinaron con otros datos del Consorcio de Genética de covid-19 del Reino Unido y el organismo sanitario Public Health England para examinar asociaciones entre la proporción a nivel regional de las infecciones y síntomas de la B.1.1.7., la duración de la enfermedad, las tasas de reinfección y la transmisibilidad.
El análisis cubrió 13 semanas en un periodo en el que la proporción de esa variante creció de manera notable en Londres, sureste y este de Inglaterra.
Claire Stevens, del King's College London, y co-líder del estudio, señaló que se confirmó "la mayor transmisibilidad (de la variante) pero también que la B.1.1.7. respondía a las medidas de confinamiento y no parecía que se escapara a la inmunidad ganada de la exposición al virus original".
El análisis no reveló asociaciones estadísticamente significativas entre la proporción de esa variante entre regiones y el tipo de síntomas experimentados por los participantes.

Ciencia y Tecnología
¿Utilizar la ivermectina en pacientes con covid-19? Esto dice la OMS
Gilson Pinargote
Además, vieron que la tasa de reinfección era baja, con solo un 0,7 % de personas que tras dar positivo en un test antes del 1 de octubre volvieron a reinfectarse más de 90 días después.
No obstante, los autores observaron que la B.1.1.7. aumentó en general el número R, en 1,35 veces frente a la cepa original.
En un comentario vinculado con el estudio, Britta Jewell, del Imperial College de Londres, apunta que la investigación refuerza el consenso de que la B.1.1.7. "tiene una mayor transmisibilidad, que ha contribuido en gran parte del agudo aumento de casos en el Reino Unido (...) así como a las actuales terceras olas que azotan países europeos con grandes cargas de casos de B.1.1.7.".